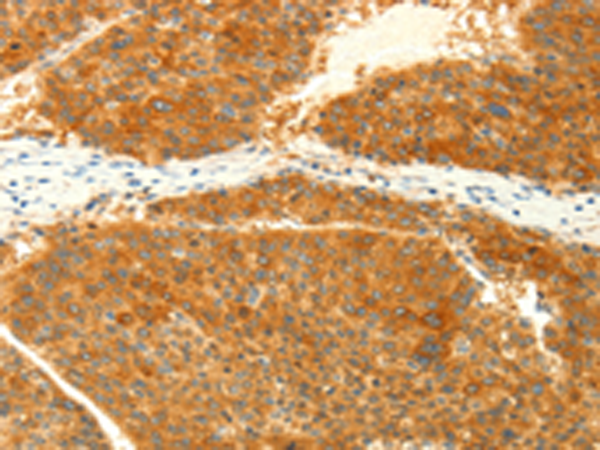

手機(jī)掃碼訪問本站

微信咨詢
中文名稱: 兔抗NAPA多克隆抗體
英文名稱: Anti-NAPA rabbit polyclonal antibody
別 名: SNAPA
抗 原: NAPA
儲(chǔ) 存: 冷凍(-20℃)
宿 主: Rabbit
相關(guān)類別: 一抗
反應(yīng)種屬: Human, Mouse, Rat
標(biāo) 記 物: Unconjugate
克隆類型: rabbit polyclonal
技術(shù)規(guī)格
|
Background: |
This gene encodes a member of the soluble NSF attachment protein (SNAP) family. SNAP proteins play a critical role in the docking and fusion of vesicles to target membranes as part of the 20S NSF-SNAP-SNARE complex. The encoded protein plays a role in the completion of membrane fusion by mediating the interaction of N-ethylmaleimide-sensitive factor (NSF) with the vesicle-associated and membrane-associated SNAP receptor (SNARE) complex, and stimulating the ATPase activity of NSF. Alternatively spliced transcript variants have been observed for this gene. |
|
Applications: |
ELISA, WB, IHC |
|
Name of antibody: |
NAPA |
|
Immunogen: |
Fusion protein of human NAPA |
|
Full name: |
N-ethylmaleimide-sensitive factor attachment protein, alpha |
|
Synonyms: |
SNAPA |
|
SwissProt: |
P54920 |
|
ELISA Recommended dilution: |
2000-5000 |
|
IHC positive control: |
Human liver cancer and Human colon cancer |
|
IHC Recommend dilution: |
25-100 |
|
WB Predicted band size: |
33 kDa |
|
WB Positive control: |
Hela and Jurkat cells, human liver cancer and mouse brain tissue |
|
WB Recommended dilution: |
500-2000 |